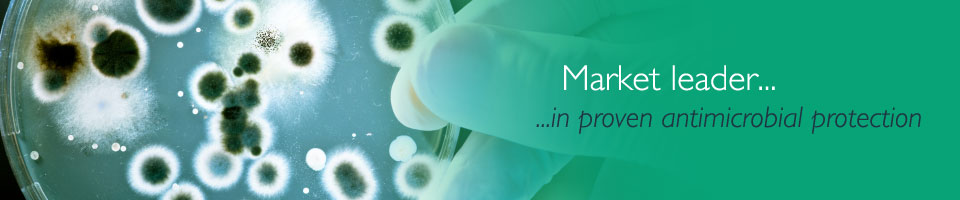

Proven Anitmicrobial Protection against Bacteria
 BioCote LogoBioCote is the market leader in proven antimicrobial protection. Biocote technology utiises inorganic silver which is the active ingredient used in Highgrade tailored solutions. Silver antimicrobial technology is proven to be safe, natural and also sustainable.
BioCote LogoBioCote is the market leader in proven antimicrobial protection. Biocote technology utiises inorganic silver which is the active ingredient used in Highgrade tailored solutions. Silver antimicrobial technology is proven to be safe, natural and also sustainable.
Highgrade protective treatments are combined with BioCote antimicrobial technology in the form of silver irons which act against harmful bacteria, damaging their cell to disrupt their normal function. This stops the bacteria from reproducing and causes them to die.
This creates an antimicrobial protection which ensures the treated areas remain bacteria free.
For more information on how Highgrade Cleaning with Biocote Protection, please follow this link Biocote Ultimate Protection
Highgrade are an approved BioCote partner, for more information on BioCote please visit www.biocote.com
Why you need BioCote
Customer case studies
- Bushey Hall Golf Club
- Wimbledon
- Family Homes
- Napoleons Casino
- Durrants Hotel
- Abbeyfield Care Home
- Brentford Football Club
Our Location
Unit 6,
Lantern Commercial Centre,
London Road,
Flamstead,
Hertfordshire,
AL3 8HG